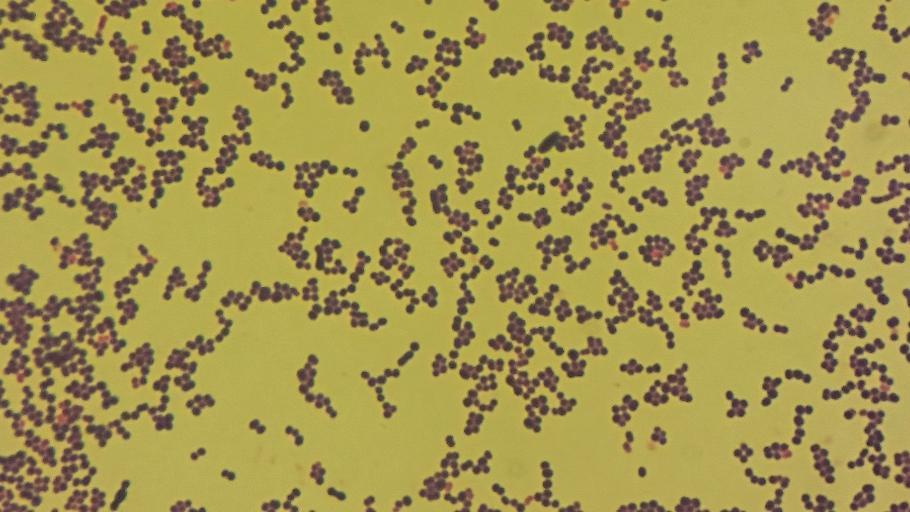

MAKE A MEME
View Large Image
| View Original: | Aerococcus urinae - microscopy.jpg (1920x1080) | |||
| Download: | Original | Medium | Small | Thumb |
| Courtesy of: | commons.wikimedia.org | More Like This | ||
| Keywords: Aerococcus urinae - microscopy.jpg Microscopy of Aerococcus urinae with gram stain showing gram positive cocci More details in source article cite journal Mattila J Häggström M 2015 Images of Aerococcus urinae https //en wikiversity org/wiki/Images_of_Aerococcus_urinae Wikiversity Journal of Medicine 2 1 10 15347/wjm/2014 013 2015-02-26 15 00 25 cite journal Mattila J Häggström M 2015 Images of Aerococcus urinae https //en wikiversity org/wiki/Images_of_Aerococcus_urinae Wikiversity Journal of Medicine 2 1 10 15347/wjm/2014 013 Mikael Häggström other versions 62 409020833333 17 304704722222 cc-zero Uploaded with UploadWizard Bacteria | ||||